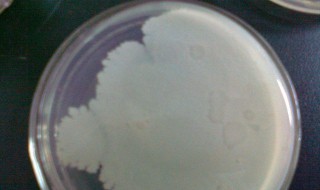
酵母菌计数为什么先盖盖玻片（酵母菌种群数量变化实验先放盖玻片）

1、酵母菌计数实验中,先盖玻璃片再加计数悬液,是因为盖玻片和计数板之间的凹槽形成的狭缝空间的体积是固定的。
2、加液体时靠虹吸作用将液体吸入;并且,如果反之,则盖玻片可能由于已加入的液滴的表面张力作用使其未能严密的盖到计数板表面上,会使计数室内的体积增大,从而使计数结果偏高。
体育百科2023-02-05 21:49:34佚名
1、酵母菌计数实验中,先盖玻璃片再加计数悬液,是因为盖玻片和计数板之间的凹槽形成的狭缝空间的体积是固定的。
2、加液体时靠虹吸作用将液体吸入;并且,如果反之,则盖玻片可能由于已加入的液滴的表面张力作用使其未能严密的盖到计数板表面上,会使计数室内的体积增大,从而使计数结果偏高。